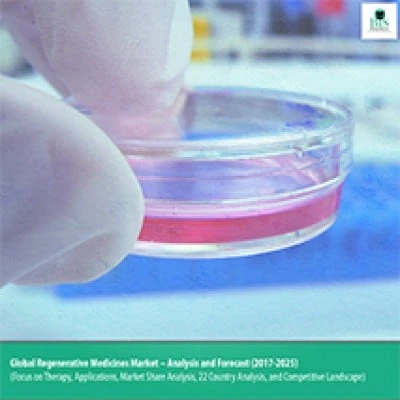
Regenerative Medicines Market - Analysis and Forecast

Engineering physics is essential in improving material science by offering a fundamental understanding of how materials behave and interact at the molecular level. With the help of this information, new materials with unique qualities suited to specific applications can be produced.
The Bansal Group of Institutes not only offers top-notch education, but they also give their albums various job options. They provide several different engineering courses, such as software, civil, computer, mechanical, and more.
Engineering Physics: What Is It?
Have you ever wondered what happens when engineering and physics come together? So, stop wondering now! The topic of engineering physics integrates the ideas of physics and engineering to create new answers to challenging issues.
In order to build and develop new technologies, materials, and systems that may be employed in a variety of industries, from aerospace to medical equipment, it is necessary to use the principles of physics. The core concept of engineering physics is applying scientific principles to practical issues.
How Does Material Science Engineering Work?
The universe of material science and engineering is right here! Engineers in the field of material science perform magic tricks to produce novel materials for a variety of uses. It encompasses everything from polymers to semiconductors to metals and ceramics.
Engineering Physics' Contribution To The Advancement Of Material Science
Not just because it sounds intriguing, engineering physics is crucial in improving material science. The following are some significant ways that engineering physics is changing the face of materials:
1. Characterization Of The Material
Engineering physics is essential to the advancement of material science through the characterization of materials. To better understand how materials can be used in various applications, it is necessary to research their physical and chemical qualities, such as their strength, durability, and conductivity.
2. Design And Development Of Materials
Engineering physics is essential for developing material science through the design and development of new materials. Engineers can produce new materials with distinctive features and applications by using physics concepts to investigate existing materials.
3. Nanomaterials And Nanotechnology
Advances in material science, particularly in nanotechnology and nanomaterials, depend heavily on engineering physics. However, these small materials have enormous potential in various industries, including health, electronics, and energy generation.
4. Optimization of Material Performance
Engineering physics is essential for developing material science and improving the performance of materials. Engineers can produce more resilient, long-lasting, and practical materials that satisfy the demands of today's industries by applying the principles of physics to the design and development of materials.
5. Modern Manufacturing Methods
Engineering physics is essential for establishing cutting-edge production methods and advancing material research.
Engineering professionals may produce more essential, long-lasting goods that are better suited to their intended use by studying the fundamental qualities of materials and using this information in the manufacturing process.
6. Sustainable Technology Materials
Engineering physics is essential for generating sustainable technologies and for advancing material research. Engineers can design and produce new materials that are more ecologically friendly, efficient, and long-lasting by researching their fundamental qualities.
Significant Engineering Physics Courses
Engineering physics prerequisite courses include:
1. Calculus
Calculus is one of the most required engineering physics courses, with numerous significant courses. In addition, students will obtain a solid understanding of mathematical ideas like derivatives and integrals in this course.
2. Mechanics
One of the leading engineering physics courses is mechanics. It deals with the investigation of motion and the driving forces behind it. Topics, including kinematics, dynamics, and statics, are covered in this course.
3. Electromagnetic Forces
Engineering physics majors frequently take physics and engineering-related courses. Electromagnetism, a required course in this area, covers subjects including electric fields, magnetic fields, and electromagnetic waves. Understanding the behaviour of electricity and magnetism in different applications, from electronics to power generation, requires completing this course.
4. Thermodynamics
For scientists and engineers who have studied modern physics, thermodynamics is an introductory course in engineering physics. It focuses on understanding heat transmission and its relation to work and energy.
5. Mechanics Of Quantum State
Quantum mechanics, electromagnetism, thermodynamics, and materials science are essential engineering topics. The introductory quantum mechanics course covers the behaviour of matter and energy at the atomic and subatomic levels.
Comprehending the characteristics of semiconductors, lasers, and other contemporary technology is crucial.
6. Materials Science Engineering
Physics includes Materials Science as one of its introductory courses. Therefore, the study of materials and their attributes, such as strength, durability, and electrical qualities, is the main topic of this course.
The Final Say
Engineering physics is essential for developing material science because it enables many materials' molecular research and experimentation.
From aerospace to medical, this has a wide range of applications. With the information and abilities you acquire through these programmes, you can improve the field of material science and have a good influence on the world.
About BGI
The Bansal Group of Institutes offers various engineering, management, and nursing courses. It has the best and top-placement colleges in its various campuses across Bhopal, Indore, and Mandideep. With credible faculty and well-equipped laboratories, BGI ensures a top-notch learning experience.
Visit Our Websites
Bhopal- https://bgibhopal.com/
Indore- https://sdbc.ac.in/
Mandideep- https://bce.ac.in/
Click on the link to get yourself registered- https://bgibhopal.com/registration-form/

Sign in to leave a comment.